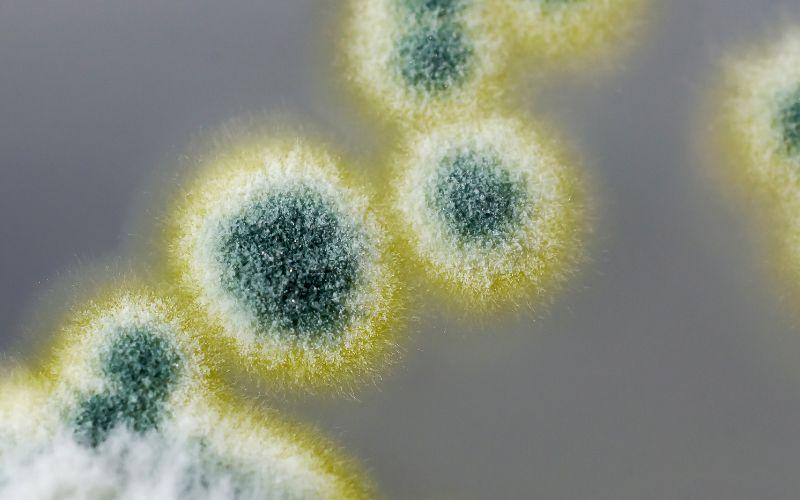

Изображения колоний гриба пеницилла

Раздел: Мир вокруг нас